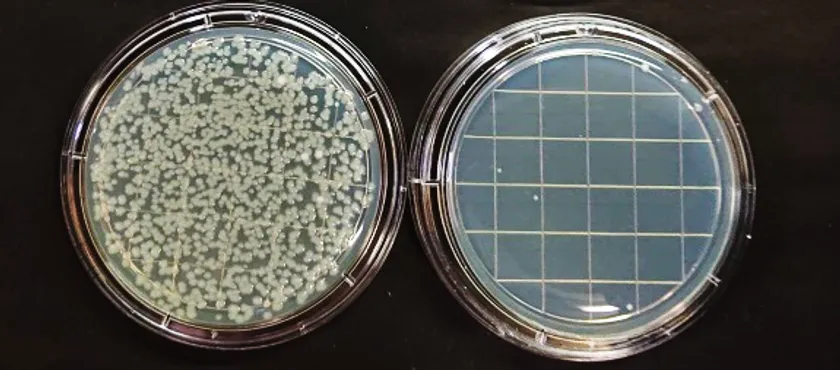

手のひらサイズの家庭用プラズマオゾン発生装置 『オゾン缶「はこべ」』を9月1日発売!(予約受付中)
株式会社紫光技研(所在地:兵庫県淡路市、代表取締役社長:脇谷 雅行)は、独自技術のプラズマ発光方式水銀フリー紫外線面光源UV-SHiPLA(UVシプラ)の新シリーズとして、小型で軽量なプラズマオゾン発生装置『オゾン缶「はこべ」』を9月1日に発売します。

オゾン缶はこべ 点灯写真
当社は元プラズマテレビ開発者が集まり、プラズマテレビ技術を紫外線発生に応用し社会に貢献すべく、紫外線デバイスの開発を続けてきました。この間、独自技術による面光源デバイスの開発に成功し、殺菌、消臭、各種検査などお客様の各種装置に採用され、実用されてきました。
しかし、昨年末より新型コロナウイルスが猛威を振るい始め、当社も直接に、新型コロナウイルス対策に貢献したいと考え始めました。その第一弾として、これまで培ってきた技術を結集し、真空紫外線を応用した安全性の高い小型の家庭用オゾン発生装置『オゾン缶「はこべ」』を開発し、来月9月1日より発売することを決定いたしました。
「はこべ」は一般家庭用として安全性を最優先にし、当社の先端技術を用いてオゾン発生量を適正に制御しています。これは、家庭用としては最高品質と自負しております。
また、「はこべ」は部屋に据え置きするだけでなく、適正な箱(プラスチック容器)と組み合わせることにより、箱の中に高いオゾン濃度を発生させ、例えばマスクやスマホなどに付着した新型コロナウイルスや大腸菌、その他の菌やウイルスなどを殺菌できるように、可搬しやすいデザインを採用しています。
皆様の、“ウィズコロナ”の生活の一助になれば幸いです。
まずは先着で100台を限定販売いたします。ただいま販売予約を受付中です。
● 製品名 :オゾン缶「はこべ」
● 発売予定日:2020年9月1日
● 予約受付 :2020年8月17日より受付中 (限定100台)
● 受付方法 :当社ホームページのお問い合わせより
http://shiko-tec.co.jp/inquiry/
● 価格 :25,000円(税別、送料別)
※2台以上お求めの方は送料当社負担(国内お届け先1か所のみ)
当社ホームページのお問い合わせページよりご連絡ください。後日メールにて購入方法をご連絡いたします。
・氏名・ご住所・ご連絡先(電話番号)・購入ご希望台数を必ずご記入ください。
※決済方法は銀行事前振込のみとなります。ご入金確認後に発送となります。
サイズ:高さ12cm×直径8cm 重さ:240g USB給電

オゾン缶はこべ 手持ち写真
6.4LのポリプロピレンBOXでの使用例

使用例 BOX殺菌
オゾン缶「はこべ」による殺菌実験 99.9%殺菌を実現(大腸菌)
左:オゾン無し(菌多数) 右:オゾン処理30分(40LBOX内にて)
殺菌実験写真
<UV-SHiPLA(シプラ)搭載の『オゾン缶「はこべ」』の特徴>
・世界で初めてプラズマテレビを開発したエンジニアが開発、製造
・真空紫外線で発生する安全なオゾンのちからで臭い、ウイルス、細菌を殺菌&消臭
・家庭用で最高レベルのオゾン発生量:4mg/時間(強、弱モードの2段切り替え)
・可搬性に優れた軽量、コンパクトな構造(サイズ 高さ12cm×直径8cm、重さ 240g)
・簡単な使い方
・BOXと組み合わせて様々な用途に使用
・性能重視で価格を極限まで低減
・USB給電
・UV-SHiPLAは水銀フリー、キセノンプラズマを利用し短波長の紫外線を効率よく発生
<オゾン缶「はこべ」の製品仕様>
サイズ :高さ12cm×直径8cm ※突起物を除く
質量 :240g
電源入力 :DC +5V 付属ACアダプタをお使いください
※モバイルバッテリ使用の場合はコネクタ形状に注意してください。
また、種類によってはご使用になれない場合があります。
電源コネクタ:USB
消費電力 :2W(弱モードは1.5W)
オゾン発生量:1時間あたり4mg(弱モードは2mg)
使用環境 :室温35℃以下の室内およびBOX内
※使用可能温度下限 0℃(結露なき事)
<注意事項>
本製品を3畳以上で部屋全体を殺菌消臭する場合のように、有人(人がいる状態)で使用する場合は、環境基準の0.1ppmを超えないように設計されています。これに対し、浴槽やトイレなど狭い部屋において無人(人がいない状態)で使用する場合は、殺菌消臭を目的としており、環境基準の0.1ppmを超える場合がありますので、必ず無人で使用する必要があります。本製品をBOX内に入れて使用する場合は、さらに高いオゾン濃度になり、10ppmに達する場合があります。BOXの蓋を開ける時は、オゾンを吸い込まないようにご注意ください。
<想定する用途>
家庭の空間を殺菌消臭。(リビング、キッチン、トイレ等 水滴のない空間)
<会社概要>
【株式会社紫光技研】
代表者 : 代表取締役社長 脇谷 雅行(わきたに まさゆき)
所在地 : 〒656-2304 兵庫県淡路市浜1-27
会社URL: http://shiko-tec.co.jp/





















